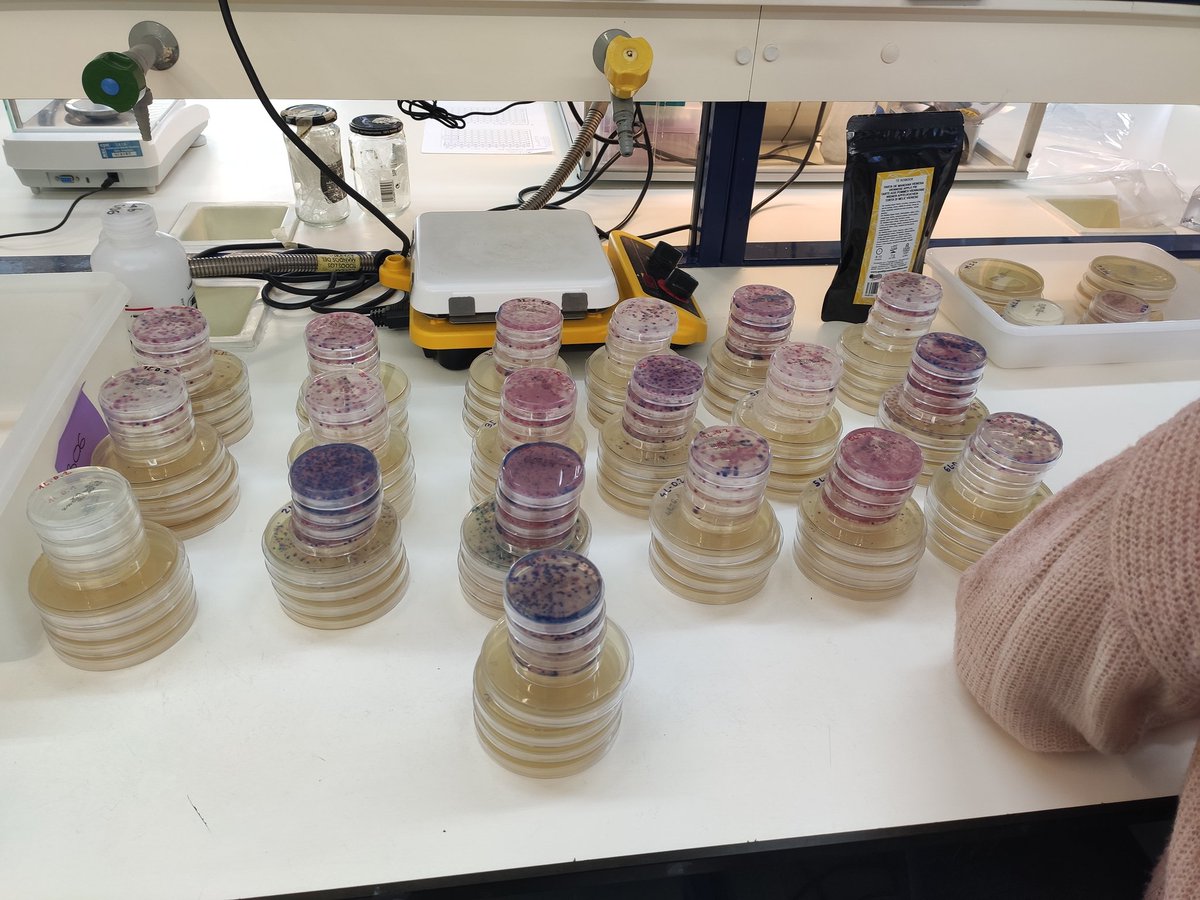
Busy week!! Lagoon project on track! Viruses, ARB, phages and microplastics #prometeo @GVAinnova

Inés Girón Guzmán
@_inesgg
🧫🫐🫑 Graduada en Ciencia y Tecnología de los Alimentos.
Máster en Calidad y Seguridad Alimentaria. Estudiante de doctorado en el grupo @VISAFELab 🫑🫐🧫
ID: 1395294527154499584
20-05-2021 08:25:26
16 Tweet
23 Takipçi
35 Takip Edilen




Grateful for all the support and contributions from everybody involved in this paper. A huge collaborative effort which makes me very proud Alba Pérez-Cataluña ANA ALLENDE IATA CSIC Iñaki Comas Nrk Walter Azahara Inés Girón Guzmán @AlvaroChiner







A customized cake prepared by Inés Girón Guzmán … dedicated to the virus with increasing concentrations in wastewater… guess which one....


Inés Girón Guzmán celebrating that #MPXV paper has just been accepted in Water Research sciencedirect.com/science/articl…


Muy orgullosos de Inés Girón Guzmán por obtener el premio de excelencia académica en el grado de CTA! innova.gva.es/es/web/univers…

Here I am!! International Association for Food Protection 's European Symposium in Food Safety 🌊🍒🔬